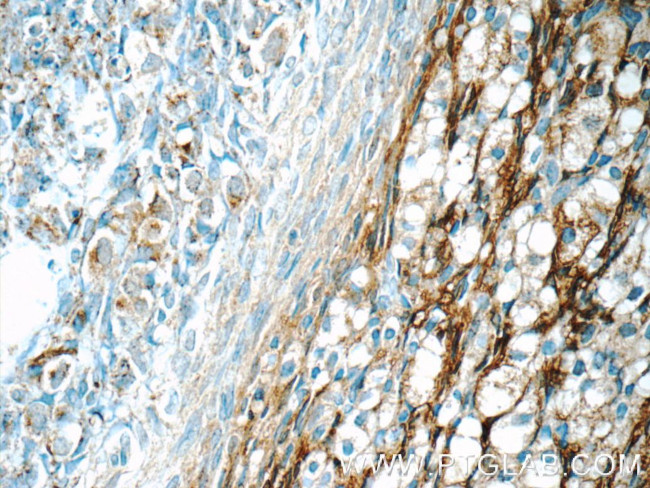
HSD17B11 Antibody in Immunohistochemistry (Paraffin) (IHC (P))

Search
Proteintech
HSD17B11 Polyclonal Antibody
{{$productOrderCtrl.translations['antibody.pdp.commerceCard.promotion.promotions']}}
{{$productOrderCtrl.translations['antibody.pdp.commerceCard.promotion.viewpromo']}}
{{$productOrderCtrl.translations['antibody.pdp.commerceCard.promotion.promocode']}}: {{promo.promoCode}} {{promo.promoTitle}} {{promo.promoDescription}}. {{$productOrderCtrl.translations['antibody.pdp.commerceCard.promotion.learnmore']}}
产品信息
16303-1-AP
种属反应
宿主/亚型
分类
类型
抗原
偶联物
形式
浓度
规格
纯化类型
保存液
内含物
保存条件
运输条件
产品详细信息
Immunogen sequence: SVTGEIVLI TGAGHGIGRL TAYEFAKLKS KLVLWDINKH GLEETAAKCK GLGAKVHTFV VDCSNREDIY SSAKKVKAEI GDVSILVNNA GVVYTSDLFA TQDPQIEKTF EVNVLAHFWT TKAFLPAMTK NNHGHIVTVA SAAGHVSVPF LLAYCSSKFA AVGFHKTLTD ELAALQITGV KTTCLCPNFV NTGFIKNPST SLGPTLEPEE VVNRLMHGIL TEQKMIFIPS SIAFLTTLER ILPERFLAVL KRKISVKFDA VIGYKMKAQ (33-300 aa encoded by BC021673)
靶标信息
Short-chain alcohol dehydrogenases, such as HSD17B11, metabolize secondary alcohols and ketones.
仅用于科研。不用于诊断过程。未经明确授权不得转售。
生物信息学
蛋白别名: 17-beta-HSD 11; 17-beta-HSD XI; 17-beta-hydroxysteroid dehydrogenase 11; 17-beta-hydroxysteroid dehydrogenase type XI; 17-beta-hydroxysteroid dehydrogenase XI; 17beta-HSD11; 17betaHSD11; 17betaHSDXI; 17bHSD11; CTCL tumor antigen HD-CL-03; CTCL-associated antigen HD-CL-03; Cutaneous T-cell lymphoma-associated antigen HD-CL-03; dehydrogenase/reductase (SDR family) member 8; Dehydrogenase/reductase SDR family member 8; Estradiol 17-beta-dehydrogenase 11; Retinal short-chain dehydrogenase/reductase 2; retinal short-chain dehydrogenase/reductase SDR2; retSDR2; Short chain dehydrogenase/reductase family 16C member 2; unnamed protein product
基因别名: 17-BETA-HSD11; 17-BETA-HSDXI; 17BHSD11; DHRS8; HSD17B11; PAN1B; PSEC0029; RETSDR2; SDR16C2; SDR2; UNQ207/PRO233
UniProt ID: (Human) Q8NBQ5, (Rat) Q6AYS8, (Mouse) Q9EQ06
Entrez Gene ID: (Human) 51170, (Rat) 289456, (Mouse) 114664